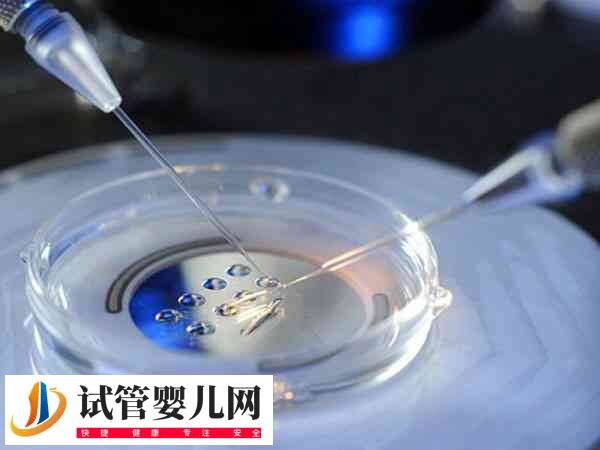
胚胎碎片率30能否移植成功(图1)

胚胎碎片率30%的胚胎,一般是可以进行胚胎移植的,不过其移植的成功率可能并不是特别高,大概在30%-40%左右,具体还要以实际情况为准。这是因为大量碎片可能导致胞浆内细胞器和供能物质减少,甚至可能导致胚胎染色体异常,从而影响胚胎的发育潜能和种植率。
胚胎碎片30%移植成功率
一般胚胎碎片率高说明胚胎染色体异常率高,这样的胚胎质量通常是不佳,而且引起胚胎异常的几率也会增加,不过胚胎碎片比例并不能直接决定胚胎移植成功率,还要结合其它指标(卵裂球数目、卵裂球均一度和卵裂球形态)来决定胚胎是否适合移植。

如果胚胎碎片30%,但细胞数量多、分裂大小均匀,形态正常的情况下,那么胚胎碎片30%移植成功率是相对比较高的,而且还能生下健康的宝宝。但也可能导致移植后的胚胎无法继续发育,最终导致移植失败,或是有移植成功,但也可能会使宝宝发育过程出现出现异常,具体还要结合实际情况进行判断。
试管婴儿胚胎碎片多该怎么办
在胚胎发育的早期阶段,胚胎的细胞可能会经历分裂和重组,但胚胎存在过多的碎片可能表明胚胎存在问题,如果大家想要了解,做试管婴儿胚胎碎片多时应该怎么处理比较好,对此感兴趣的可以参考下列方式改善。
1、调整生活习惯
试管婴儿胚胎碎片多,可能是由于胚胎质量不佳引起的现象,而这与精子和卵子的质量及身体健康状态有关,对此建议患者可以通过调整生活健康的习惯,比如注意多休息,避免过度劳累,多吃健康的饮食,能够为胚胎发育提供营养支持。
2、优化胚胎培养液
患者做试管胚胎碎片多时,可以通过优化囊胚培养液,模拟自然环境,为胚胎提供最适合其生长发育的条件,从而降低胚胎碎片的产生,或是在胚胎培养过程中,通过延长培养时间,这样也可以改善试管婴儿胚胎碎片多的情况。

3、定期检查
做试管婴儿胚胎碎片多的患者,如果已经进行了胚胎移植,那么可能会存在较大的流产几率,建议这时的患者除了要尽量卧床休息外,还要注意在医生的指导下做好定期检查,并遵医嘱服用黄体酮胶囊等药物进行保胎处理。
4、药物治疗
如果多次出现试管婴儿胚胎碎片多的现象,建议患者最好及时在医生的指导下进行药物治疗,以改善身体病理状态,这样能够提高卵子的质量,减少胚胎碎片多的可能,同时还能提高试管婴儿的成功几率。






